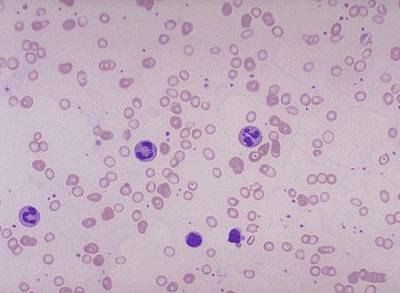
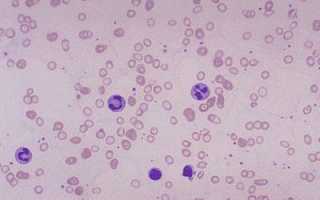

Содержание
Гипохромная анемия – это общий термин для нескольких форм малокровия, при которых недостаток гемоглобина вызывает снижение цветового показателя. На степень насыщенности эритроцита гемоглобином указывает степень его окраски. Здоровая красная клетка характерна равномерным розовым окрасом, с небольшим просветлением в центре. При снижении уровня гемоглобина он бледнеет, а светлая площадь в центре становится более обширной, что характеризуется как гипохромия.
Что такое гипохромия
Гипохромией называют состояние, характерное сниженным количеством гемоглобина в красных клетках крови.
Гипохромные анемии подразделяются на следующие виды:
- Железораспределительная. Возникает при нарушении механизма изъятия железа из депо на фоне туберкулеза, эндокарита, гнойных воспалительных и других инфекционных болезней.
- Железонасыщенная. Возникает при достаточных запасах железа, которое не используется для синтеза гемоглобина. Это наблюдается при накоплении Fe после разрушения эритроцитов, интоксикаций различными ядами или соединениями тяжелых металлов, после приема некоторых препаратов. К данному виду анемии относится и микроцитоз.
- Железодефицитная. Выявляется наиболее часто, и возникает при нехватке железа после кровотечений, нарушений усвоения пищи или механизма всасывания, особенно при высокой потребности в микроэлементе или нехватке железа в продуктах питания.
- Смешанная, при которой сочетаются несколько факторов, имеющих или не имеющих взаимных связей. Такими сочетаниями могут быть инфекционное заболевание у вегетарианца, беременность и недостаток питания, проведение оперативного вмешательства в ЖКТ и анемия.
В процессе описания анализа крови при обнаружении гипохромии обязательно указывают одну из трех ее степеней:
- Первая. Характеризуется четко заметной под микроскопом светлой зоны по центру эритроцита, которая визуально более широкая в сравнении с нормально окрашенным.
- Вторая. Окрас заметен только на периферии эритроцита.
- Третья. Когда окрашивание осталось только в оболочке эритроцита.
Любая степень гипохромной анемии классифицируется по уровню содержания в крови гемоглобина. Так, первой степени соответствует 90 г/л, второй – 90-70 г/л, падение меньше 70 г/л означает наступление тяжелой, или третьей степени.
Врачи отмечают, что гипохромия эритроцитов является важным клиническим признаком, указывающим на возможные нарушения в организме. Этот феномен, характеризующийся снижением содержания гемоглобина в красных кровяных клетках, часто свидетельствует о железодефицитной анемии. Специалисты подчеркивают, что выявление гипохромии требует внимательного анализа и комплексного подхода к диагностике. Важно учитывать не только лабораторные показатели, но и клинические симптомы, такие как усталость, бледность кожи и одышка. Врачи рекомендуют проводить регулярные обследования, особенно для групп риска, чтобы своевременно выявить и устранить причины гипохромии, что позволит избежать серьезных осложнений и улучшить качество жизни пациентов.

Симптомы
Точно определить наличие гипохромии по внешним признакам невозможно, но любое анемическое состояние характеризуется сходными симптомами (включая микроцитоз), при появлении которых необходимо обратиться к терапевту или гематологу, которые назначат сдачу крови и другие необходимые обследования.

- Головокружение, ощущение слабости, обморок и мелькание мушек перед глазами.
- Быстро наступающая усталость, отсутствие возможности длительное время заниматься физическим или интеллектуальным трудом.
- Бледность кожных покровов, синий оттенок под глазами (анемичный вид).
- Повышенная раздражительность и беспричинная плаксивость у женщин.
- Периодические приступы сердцебиения и тахикардия в состоянии покоя.
- Одышка.
Косвенно наличие у человека анемии можно проверить реакцией организма на прием железосодержащих препаратов. При анемии, вызванной нехваткой железа, такие люди ощущают улучшение самочувствия. Но при железонасыщенном и железораспределительном малокровии прием подобных лекарств эффекта не приносят.
Необходимые исследования после появления симптомов
Для уточнения диагноза гипохромии, врач назначает проведение лабораторных анализов, где исследуют размер, форму и число эритроцитов, кол-во гемоглобина в крови и ЦП.
Так, на заболевание гипохромией указывают следующие лабораторные показатели:
- Выявление заболевания в общем анализе крови.
- Цветовой показатель опустился ниже 0,85.
- Сыворотка крови содержит недостаточное количество сывороточного железа.
Гипохромия эритроцитов — это состояние, при котором красные кровяные клетки имеют пониженное содержание гемоглобина, что приводит к их бледному цвету. Многие люди, столкнувшиеся с этой проблемой, отмечают, что это может быть признаком различных заболеваний, таких как железодефицитная анемия. В обсуждениях на форумах часто упоминается, что важно не игнорировать симптомы, такие как усталость, слабость или одышка. Пользователи делятся своим опытом: некоторые нашли решение в изменении рациона, включая больше продуктов, богатых железом, такие как мясо, бобовые и зелень. Другие же подчеркивают важность регулярных медицинских обследований, чтобы вовремя выявить и устранить причины гипохромии. В целом, общественное мнение акцентирует внимание на необходимости комплексного подхода к здоровью и важности самодиагностики.

Причины

- Значительные кровотечения (при операциях, родах или травмах).
- После внутренних кровоизлияний, которые не обязательно сопряжены с существенными кровопотерями. Заболевание способно развиваться после незначительных, но постоянных кровотечений.
- Неправильное питание, при котором ограничено поступление продуктов, богатых железом: мяса, чернослива, яблок, кураги.
- Период беременности, при котором железа требуется значительно больше в сравнении с нормой для взрослого человека.
- Болезни ЖКТ, при которых нарушается усвоение железа, и в организме образуется его нехватка даже при достаточном поступлении с пищей.
- Частая сдача крови при донорстве.
- Врожденная детская гипохромия (микроцитоз) и другие наследственные патологии, характерные блокированием синтеза гемоглобина.
- Гельминтоз.
Лечение
Гипохромия эритроцитов лечится устранением причины патологии одновременно с симптоматической терапией, а также нормализацией обмена железа в организме.
Так, в зависимости от вида малокровия, терапевтические меры будут следующие:

- Организация сбалансированного питания;
- При наличии острого кровотечения его останавливают при помощи препаратов, повышающих свертываемость крови;
- При хроническом кровотечении в органах пищеварения проводят дополнительные обследования и лечение обнаруженного источника: варикоза вен пищевода и желудка, эрозий или осложнений после операции;
- При тяжелом течении болезни производят введение эритроцитарной массы и препаратов железа.
Железодефицитная и железораспределительная анемия лечатся устранением сопутствующих заболеваний, которые привели к болезни, а также приемом витаминных комплексов или витамина В6.
Лечение талассемии (генетически обусловленный микроцитоз) серьезной ремиссии не дает, но заметно улучшает качество жизни пациента. Железосодержащие препараты в данном случае противопоказаны, так как микроцитоз характеризуется избытком железа в организме.
Если при лечении гипохромии происходит значительное увеличение размеров селезенки, а к симптомам анемии добавляются лейкопения и тромбоцитопения, проводят спленэктомию.

Опасности заболевания

- Ослабление иммунитета.
- Развитие кардиомиопатии – работа сердечной мышцы с удвоенной силой при нехватке кислорода, что ведет к сердечной недостаточности.
- Отрицательное влияние на нервную систему.
- Увеличение печени.
- Хроническое малокровие.
Профилактика

Гипохромия – это патология, характеризующаяся пониженным содержанием гемоглобина в эритроцитах.
Она может развиваться при недостатке поступления или нарушениях процесса усвоения железа в организме. При появлении характерных симптомов необходимо пройти обследование для выявления причины заболевания, так как на основании характерных признаков поставить точный диагноз невозможно. При отсутствии генетической предрасположенности к гипохромии (врожденный микроцитоз), ее появление возможно предотвратить при помощи профилактических мер.
Вопрос-ответ
Что такое гипохромия эритроцитов и как она проявляется?
Гипохромия эритроцитов — это состояние, при котором красные кровяные клетки имеют пониженное содержание гемоглобина, что приводит к их бледному цвету. Это может проявляться в виде усталости, слабости, одышки и других симптомов анемии, так как сниженное количество гемоглобина затрудняет транспортировку кислорода к тканям организма.
Какие причины могут привести к гипохромии эритроцитов?
Основными причинами гипохромии являются дефицит железа, хронические заболевания, такие как хроническая болезнь почек, а также некоторые генетические расстройства. Недостаток витаминов, таких как B12 и фолиевая кислота, также может способствовать развитию этого состояния.
Как диагностируется гипохромия эритроцитов?
Диагностика гипохромии обычно начинается с общего анализа крови, который показывает уровень гемоглобина и цветовой индекс эритроцитов. Врач может также назначить дополнительные тесты, такие как анализ на уровень железа в крови, чтобы определить причину гипохромии и назначить соответствующее лечение.
Советы
СОВЕТ №1
Обратите внимание на симптомы. Гипохромия эритроцитов может проявляться в виде усталости, слабости, бледности кожи и одышки. Если вы заметили у себя эти признаки, стоит обратиться к врачу для обследования.
СОВЕТ №2
Следите за своим рационом. Недостаток железа, витаминов B12 и фолиевой кислоты может привести к гипохромии. Включите в свой рацион продукты, богатые этими веществами, такие как мясо, рыба, яйца, бобовые и зеленые листовые овощи.
СОВЕТ №3
Регулярно проходите медицинские обследования. Анализы крови помогут выявить изменения в уровне гемоглобина и эритроцитов на ранних стадиях. Это позволит своевременно принять меры и избежать осложнений.
СОВЕТ №4
Обсудите с врачом возможные причины гипохромии. Это может быть связано не только с дефицитом питательных веществ, но и с хроническими заболеваниями. Важно выяснить первопричину, чтобы выбрать правильное лечение.